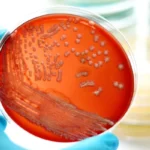
red bacteria 6

Advantages of Installing a Soft Water System
- Published:
- Updated: January 16, 2025
Summary
Installing a soft water system offers numerous benefits, including enhanced appliance longevity, better energy efficiency, improved cleaning results, and healthier skin and hair. These systems also reduce environmental impact and provide cost savings over time.
- Soft water prevents scale buildup, extending appliance life and reducing maintenance costs.
- It improves cleaning results by enhancing soap efficiency and reducing chemical usage.
- Environmental benefits include reduced chemical discharge, and the long-term cost savings make it a wise investment.
In today’s world, where water quality is paramount, understanding the benefits of a soft water system is crucial. Whether you’re an environmental science student or a homeowner facing water quality challenges, the insights provided here aim to simplify complex scientific concepts and offer practical advice based on decades of experience in water quality analysis and environmental consulting. As water quality continues to be a pressing issue globally, equipping oneself with knowledge about soft water systems can pave the way for healthier living environments and more sustainable practices. This article delves deep into the myriad advantages of soft water systems, providing a comprehensive guide for those considering making the switch.
Understanding Soft Water
Before delving into the advantages, it’s essential to comprehend what soft water is. Soft water is water that contains low concentrations of calcium and magnesium ions. Unlike hard water, which can lead to scale buildup and various inefficiencies, soft water is free from these mineral deposits, offering numerous benefits for both residential and commercial applications. The absence of these minerals not only prevents plumbing and appliance issues but also enhances the overall quality of water, making it more suitable for everyday use. Moreover, soft water’s unique properties provide a cleaner and more efficient water experience, making it a preferred choice for many households and businesses.
Understanding the science behind soft water further underscores its advantages. In a soft water system, the calcium and magnesium ions typically found in hard water are replaced with sodium or potassium ions through a process known as ion exchange. This transformation significantly reduces the potential for scale formation, which can obstruct pipes and damage appliances. Furthermore, without the interference of hard minerals, water can perform its natural functions more effectively, such as dissolving cleaning agents, which leads to better cleaning outcomes. By appreciating these underlying principles, one can fully grasp why soft water systems are becoming an essential component of modern water management solutions.
Key Benefits of a Soft Water System
Enhancing Appliance Longevity
One of the primary advantages of installing a soft water system is the enhancement of appliance longevity. Hard water can lead to scale buildup in appliances such as dishwashers, washing machines, and water heaters, causing them to operate inefficiently and eventually break down. By using soft water, these appliances function more efficiently and have a prolonged lifespan. This not only saves on repair and replacement costs but also ensures that appliances run smoothly, maintaining their performance over time.
Moreover, the prevention of scale buildup means that appliances require less frequent maintenance and cleaning. The internal components of appliances, which are often prone to corrosion and mineral deposits, remain clean and functional for longer periods. This not only reduces the frequency of professional servicing but also minimizes the risk of unexpected breakdowns. In a world where appliances are significant investments, ensuring their longevity through soft water can lead to substantial savings and peace of mind for homeowners and businesses alike.
Improved Energy Efficiency
Soft water plays a significant role in improving energy efficiency. Water heaters, for instance, can operate more effectively without the obstruction of scale deposits. This results in lower energy consumption and reduced utility bills. According to the Water Quality Research Foundation, water heaters using soft water maintain their efficiency over time, compared to those using hard water, which can lose up to 48% of efficiency. This stark contrast highlights how soft water systems can contribute to long-term energy savings.
Additionally, the enhanced efficiency extends beyond water heaters. Other appliances that use water, such as washing machines and dishwashers, also benefit from reduced energy consumption when operating with soft water. The decreased energy demand not only lowers monthly utility bills but also contributes to a lower carbon footprint, aligning with broader environmental goals. By fostering a more energy-efficient household or business, soft water systems play a vital role in sustainable living and environmental stewardship.

Better Cleaning Results
Soft water leads to superior cleaning outcomes. The absence of calcium and magnesium ions means that soaps and detergents can dissolve more effectively, reducing the amount required for cleaning. This not only saves money but also reduces the environmental impact of detergent usage. Clothes washed in soft water are softer, whites remain white, and there are no soap residues left on dishes or glassware. This results in a noticeable difference in the quality of cleaning, with softer fabrics and sparkling clean surfaces.
Furthermore, the improved solubility of cleaning agents in soft water reduces the need for repeated washing and rinsing cycles, saving both time and water. Households and businesses can enjoy cleaner laundry, spotless dishes, and residue-free surfaces with less effort. The enhanced cleaning power of soft water also means fewer chemicals are needed to achieve desired results, which is beneficial for those with sensitive skin or allergies. By optimizing cleaning processes, soft water systems contribute to both personal well-being and environmental conservation.
Skin and Hair Health
For those concerned with personal care, the benefits of soft water extend to skin and hair health. Hard water can leave a residue that clogs pores and leaves hair feeling dry and brittle. Soft water, by contrast, allows soap and shampoo to rinse away thoroughly, leaving skin softer and hair more manageable. The gentle nature of soft water can alleviate skin conditions such as eczema and dermatitis, providing relief for those with sensitive skin.
Additionally, the absence of harsh minerals in soft water means that hair retains its natural oils, preventing dryness and breakage. This results in smoother, shinier hair that is easier to style and maintain. The use of soft water can lead to a noticeable improvement in overall personal grooming routines, enhancing both appearance and comfort. By promoting healthier skin and hair, soft water systems offer significant benefits for personal well-being and confidence.
Environmental and Economic Impacts
Reduction in Chemical Usage
The environmental benefits of soft water are also noteworthy. By using less soap and detergent, there is a corresponding reduction in chemical discharge into wastewater systems. This reduction is beneficial for the environment, as it decreases the pollutant load on sewage treatment plants and water bodies. The decreased reliance on harsh cleaning agents also means a reduced impact on aquatic ecosystems, promoting healthier waterways and biodiversity.
Furthermore, the reduced chemical usage aligns with broader efforts to minimize environmental footprints and promote sustainable living. Households and businesses that switch to soft water systems contribute to a cleaner environment by reducing the release of phosphates and other harmful substances into the ecosystem. This proactive approach to environmental responsibility not only benefits local communities but also supports global conservation efforts. By choosing soft water systems, individuals and organizations can play a part in protecting the planet for future generations.
Cost Savings
While the initial investment in a soft water system may seem substantial, the long-term savings are significant. Reduced repair and replacement costs for appliances, lower energy bills, and decreased soap and detergent purchases all contribute to the economic benefits of soft water systems. The cumulative savings over time can offset the initial installation costs, making it a financially sound investment.
Moreover, the cost savings extend to other areas, such as reduced maintenance expenses and longer appliance lifespans. As appliances and plumbing systems experience less wear and tear, the need for costly repairs and replacements diminishes. This not only frees up household or business budgets for other priorities but also enhances overall financial stability. By investing in a soft water system, individuals and organizations can enjoy both immediate and long-term economic advantages, leading to a more prosperous future.
Practical Implementation of Soft Water Systems
Types of Soft Water Systems
There are several types of soft water systems available, each with its unique mechanism and suitability for different situations. The most common type is the ion-exchange system, which replaces calcium and magnesium ions with sodium or potassium ions. Other systems include salt-free water conditioners and reverse osmosis systems, each with their specific applications and benefits. Understanding the differences between these systems can help consumers select the most appropriate option for their needs.
Ion-exchange systems are favored for their efficiency and reliability, making them a popular choice for many households. Salt-free water conditioners, on the other hand, are suitable for those concerned about sodium intake or environmental impact, as they use alternative methods to prevent scale without altering water chemistry. Reverse osmosis systems offer a comprehensive water purification solution, removing not only hardness but also contaminants such as chlorine and heavy metals. By exploring the various types of soft water systems, individuals can make informed decisions that align with their preferences and requirements.
Installation Considerations
When considering the installation of a soft water system, it is essential to assess water usage patterns, the hardness level of the water, and any specific requirements related to space and budget. Consulting with a water quality expert can provide valuable insights and help tailor the system to meet specific needs. A thorough assessment ensures that the chosen system effectively addresses the unique challenges of the household or business.
Additionally, planning for installation involves evaluating existing plumbing infrastructure and any necessary modifications. Understanding the spatial requirements and potential adjustments needed for the system’s integration can streamline the installation process and minimize disruptions. By taking a proactive approach to installation considerations, individuals can ensure a smooth transition to a soft water system, maximizing its benefits from day one.
Maintenance Requirements
Regular maintenance of a soft water system is crucial to ensure its efficiency and longevity. This includes periodic checks of the ion-exchange resin, replenishing salt or potassium levels, and monitoring the system for any signs of malfunction. Proper maintenance not only extends the lifespan of the system but also ensures optimal performance. Routine inspections and timely interventions can prevent minor issues from escalating into major problems.
Moreover, staying on top of maintenance tasks can help identify potential improvements or upgrades to enhance system functionality. Engaging with professional maintenance services or following manufacturer guidelines can provide the necessary support to keep the system running smoothly. By prioritizing maintenance, individuals can protect their investment in a soft water system and continue to enjoy its numerous advantages.
Addressing Common Concerns
Health Implications
A common concern regarding soft water systems is the increased sodium content in the water. While the amount added is generally minimal and safe for consumption, individuals on sodium-restricted diets may prefer potassium-based systems or consult with a health professional. Understanding the specific needs and health considerations of household members can guide the selection of the most appropriate system.
Furthermore, advancements in soft water technology have led to the development of systems that minimize sodium content without compromising effectiveness. These innovations provide reassurance for those with dietary restrictions or health concerns. By staying informed about the latest developments, individuals can make choices that align with their health priorities while still benefiting from the advantages of soft water.
Environmental Responsibility
For those concerned about the environmental impact of sodium discharge, modern soft water systems offer eco-friendly options. Salt-free systems and advancements in ion-exchange technology provide solutions that minimize environmental footprints while delivering the benefits of soft water. These systems are designed to balance effectiveness with sustainability, ensuring that environmental considerations are not overlooked.
Additionally, choosing eco-friendly soft water solutions aligns with broader efforts to reduce environmental impact and promote green living. By opting for systems that prioritize sustainability, individuals and organizations can demonstrate their commitment to protecting the planet. This responsible approach not only benefits the environment but also resonates with consumers and stakeholders who value ecological stewardship. By integrating eco-friendly soft water systems, individuals can enjoy the advantages of soft water while contributing to a more sustainable future.
Conclusion
Installing a soft water system offers a multitude of advantages, from enhancing appliance efficiency to improving personal care and reducing environmental impact. By understanding and implementing the right system, individuals can enjoy these benefits while contributing to sustainable water management practices. Whether you’re a student, homeowner, or professional, the insights offered here aim to provide clarity and guidance on the subject of soft water systems.
In the quest for improved water quality, soft water systems represent a valuable investment in both economic and environmental terms, ensuring a healthier and more efficient home or business environment. As water quality challenges persist, adopting soft water solutions can lead to significant improvements in daily living and long-term sustainability. By embracing the benefits of soft water, individuals and organizations can pave the way for a cleaner, more efficient, and more responsible future.
Share this on social media: